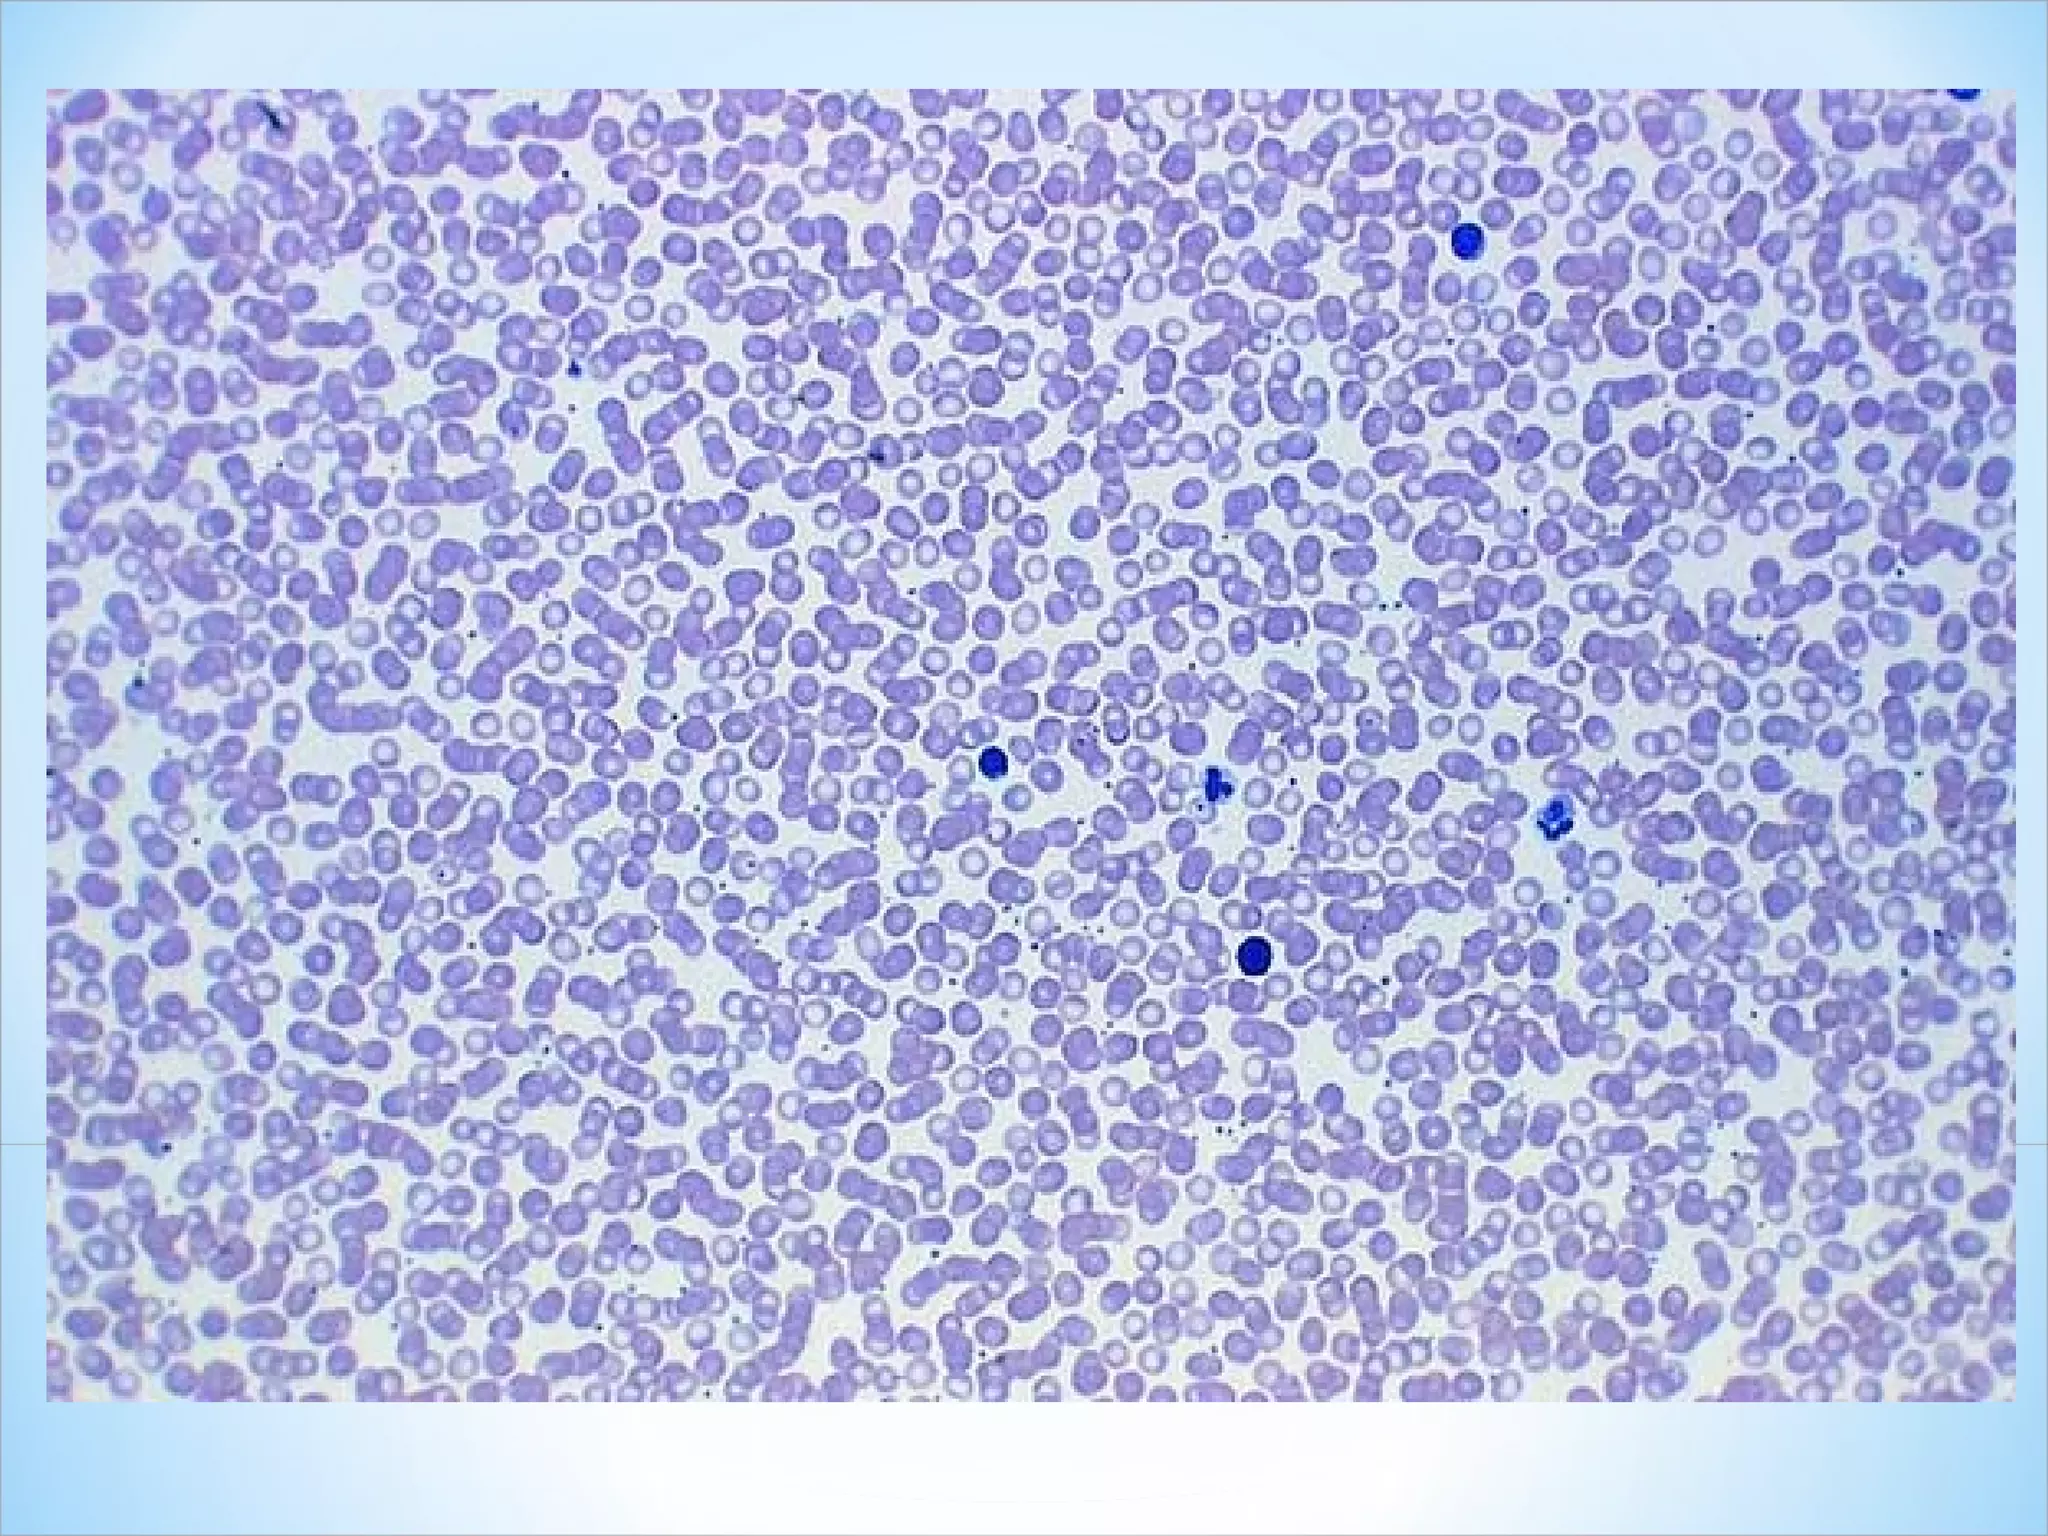
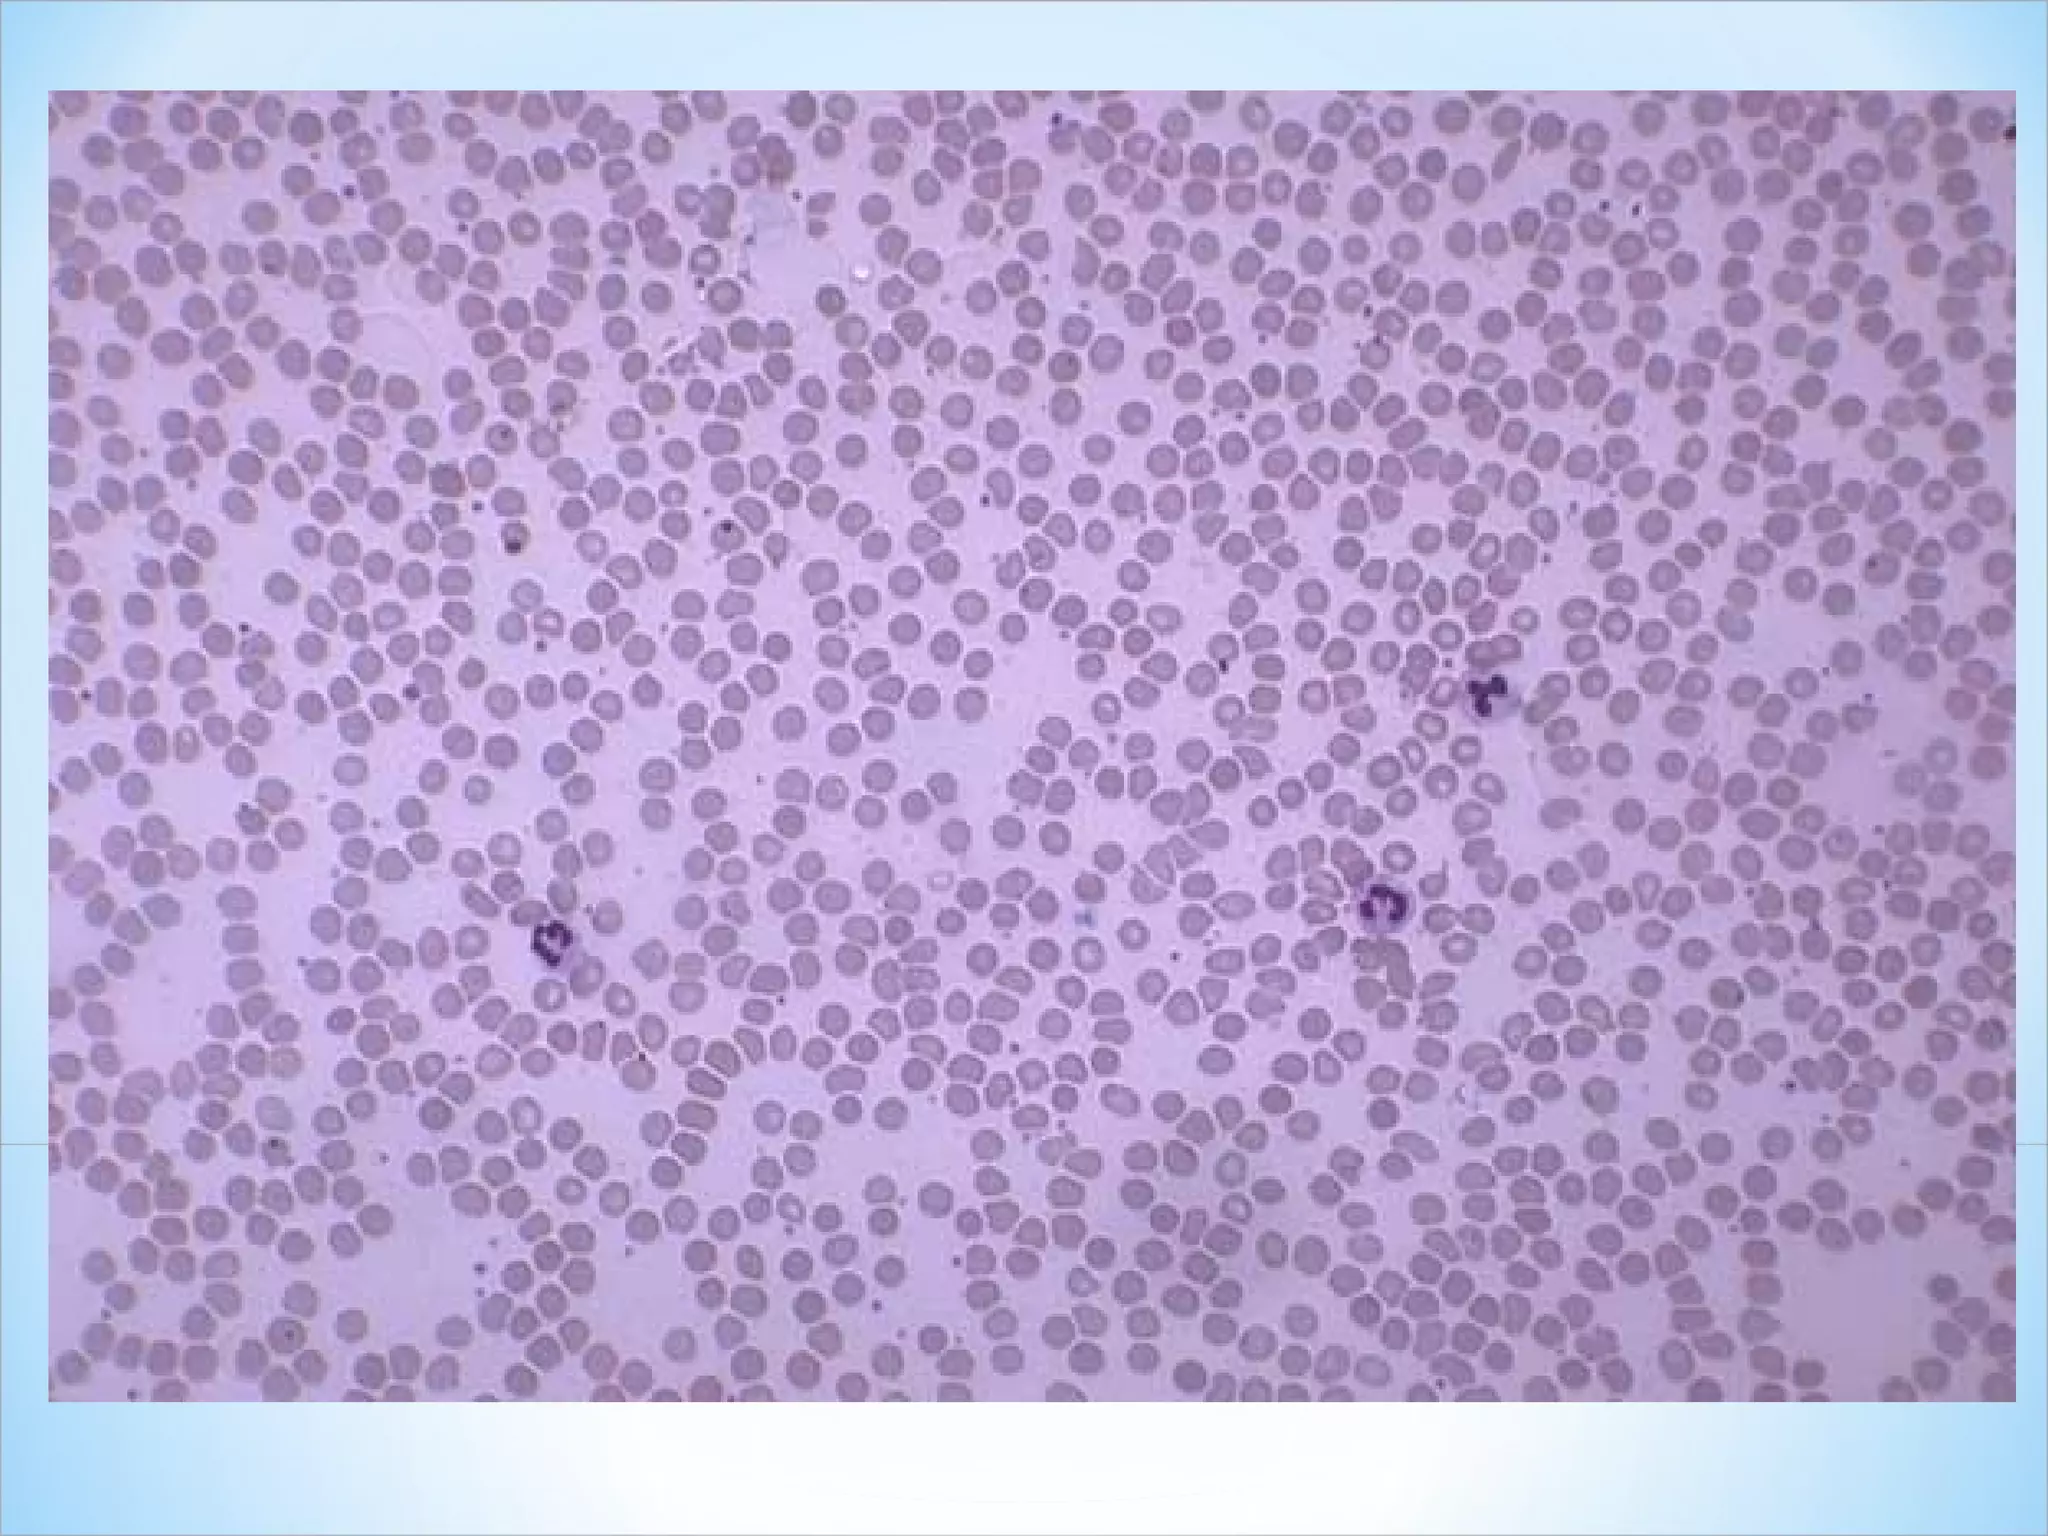
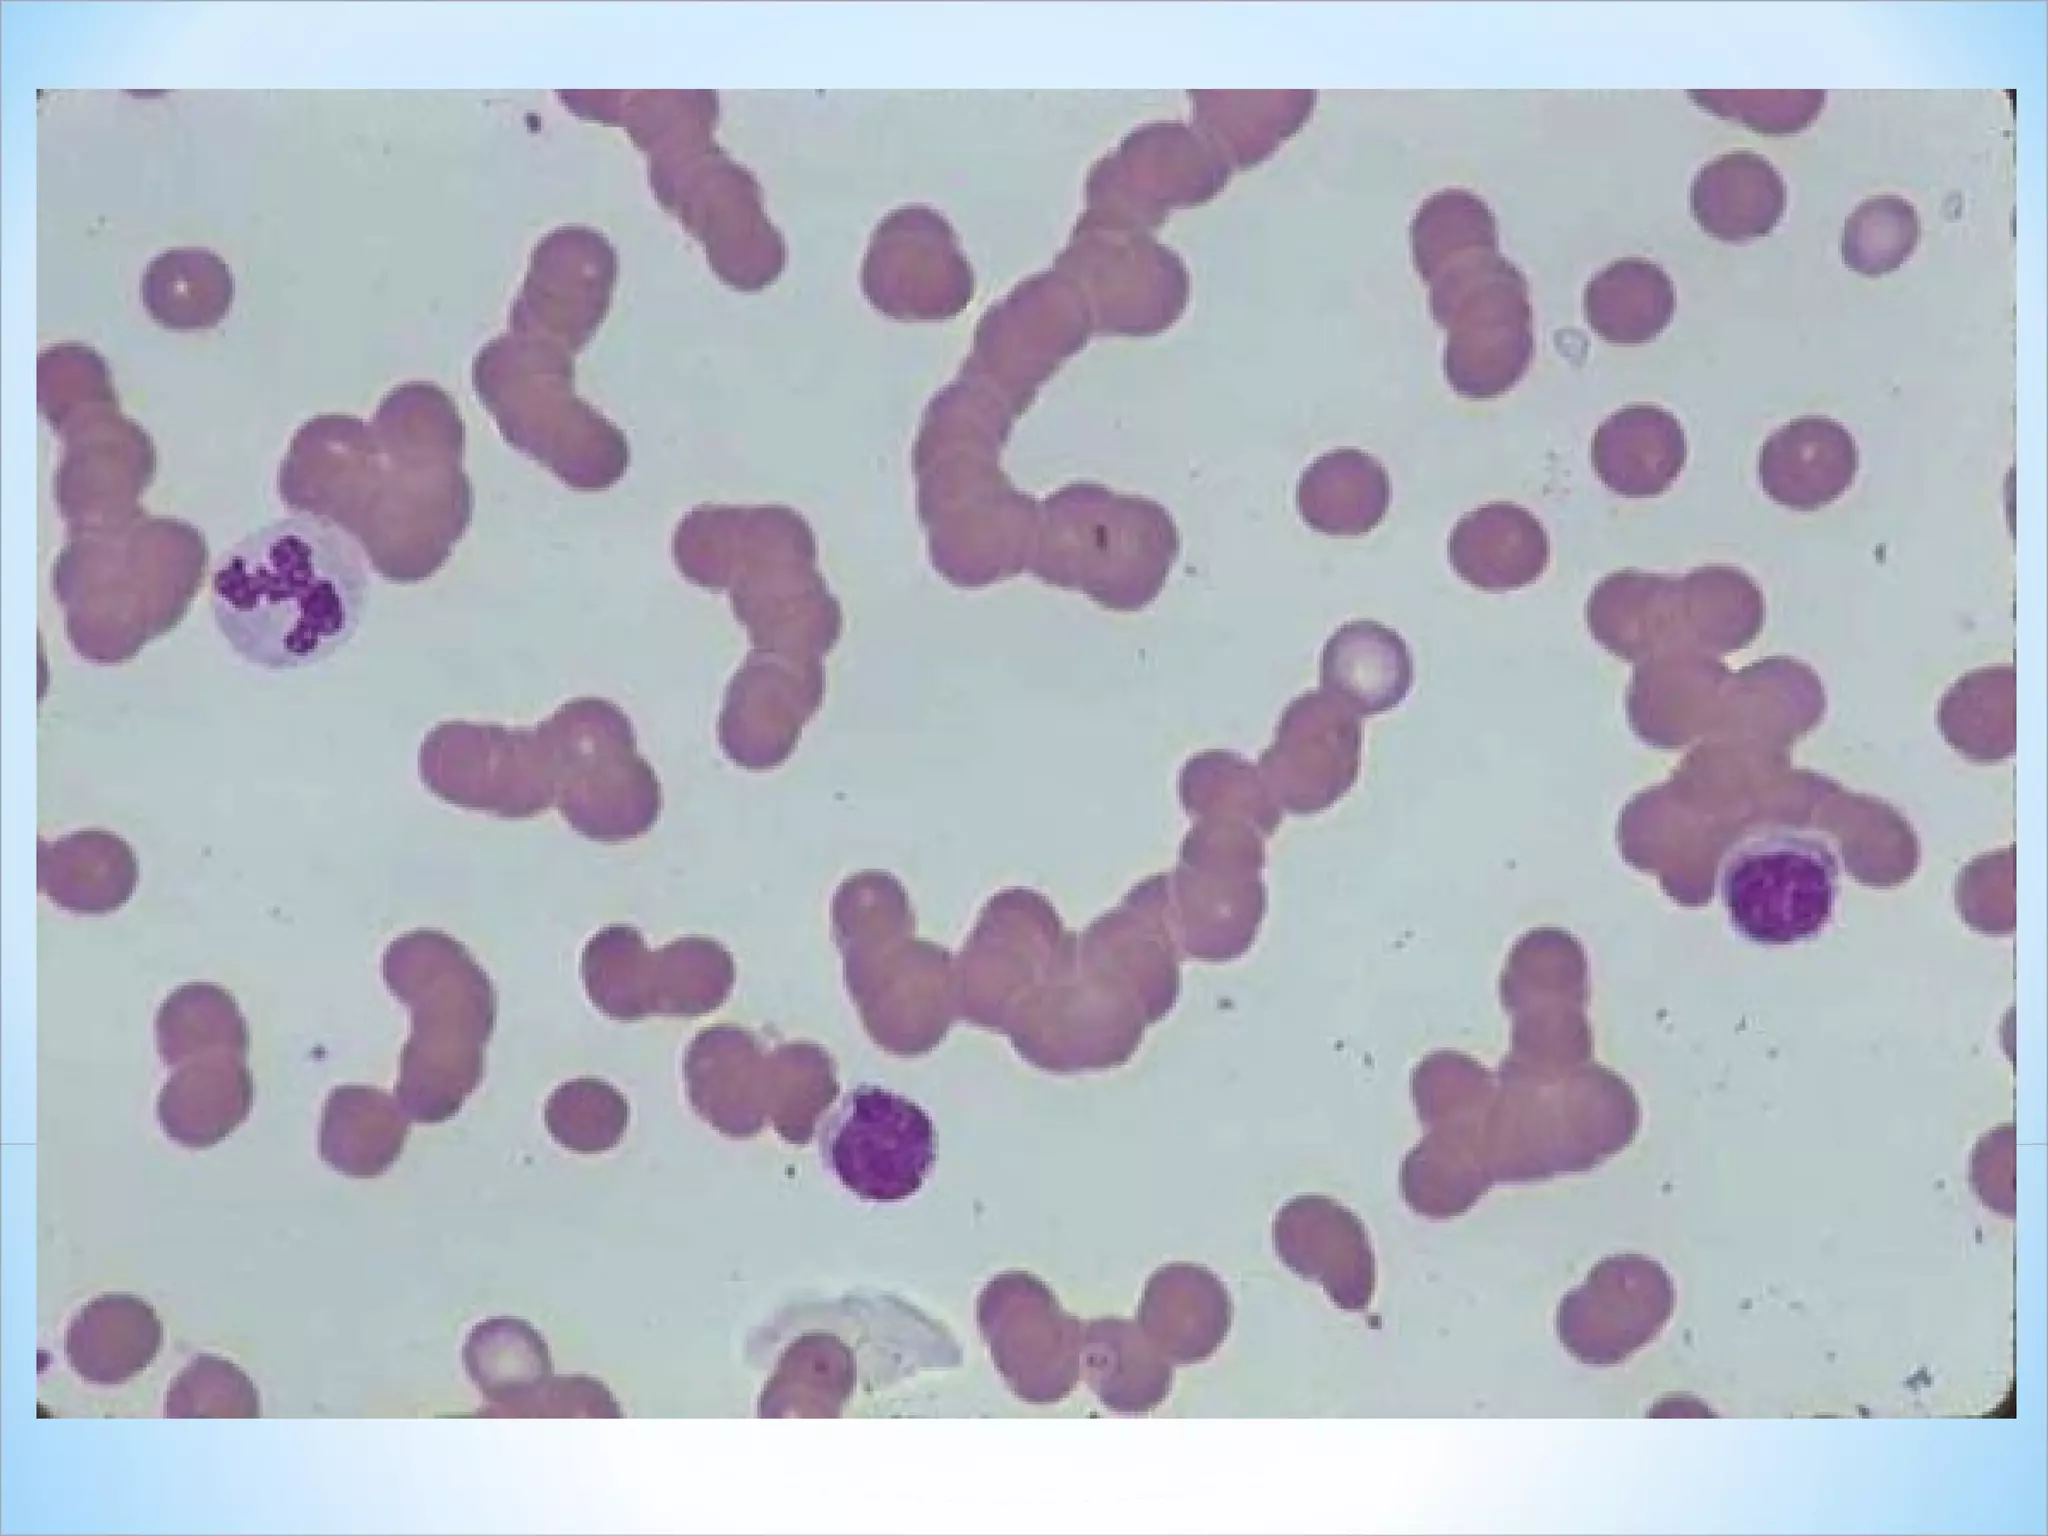
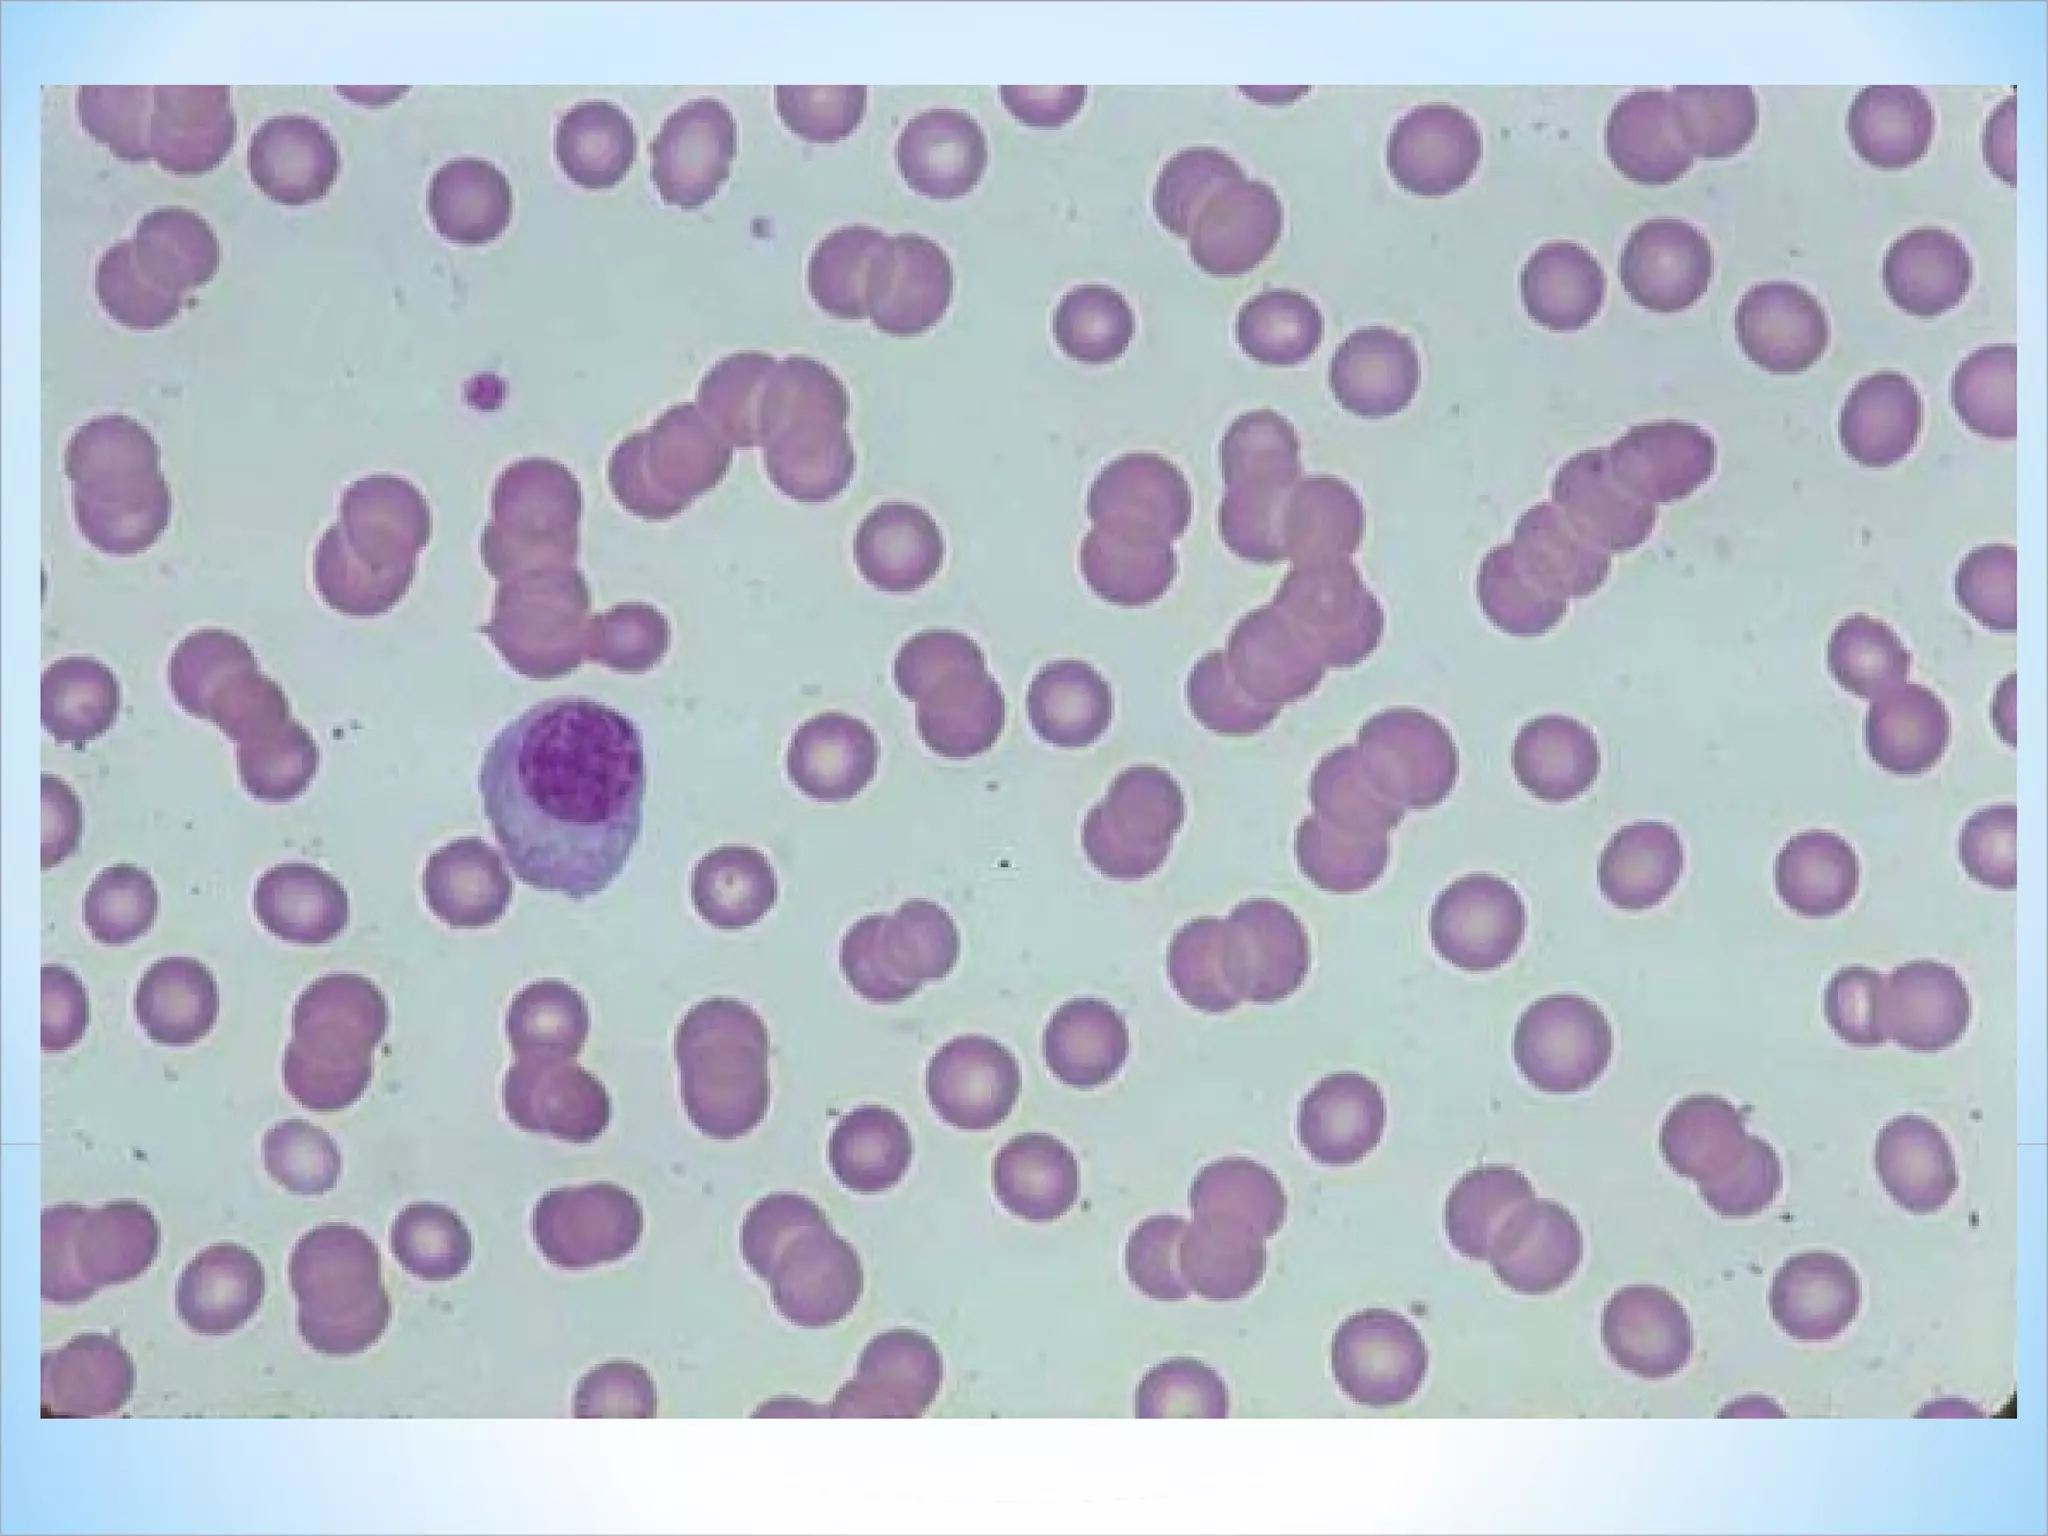
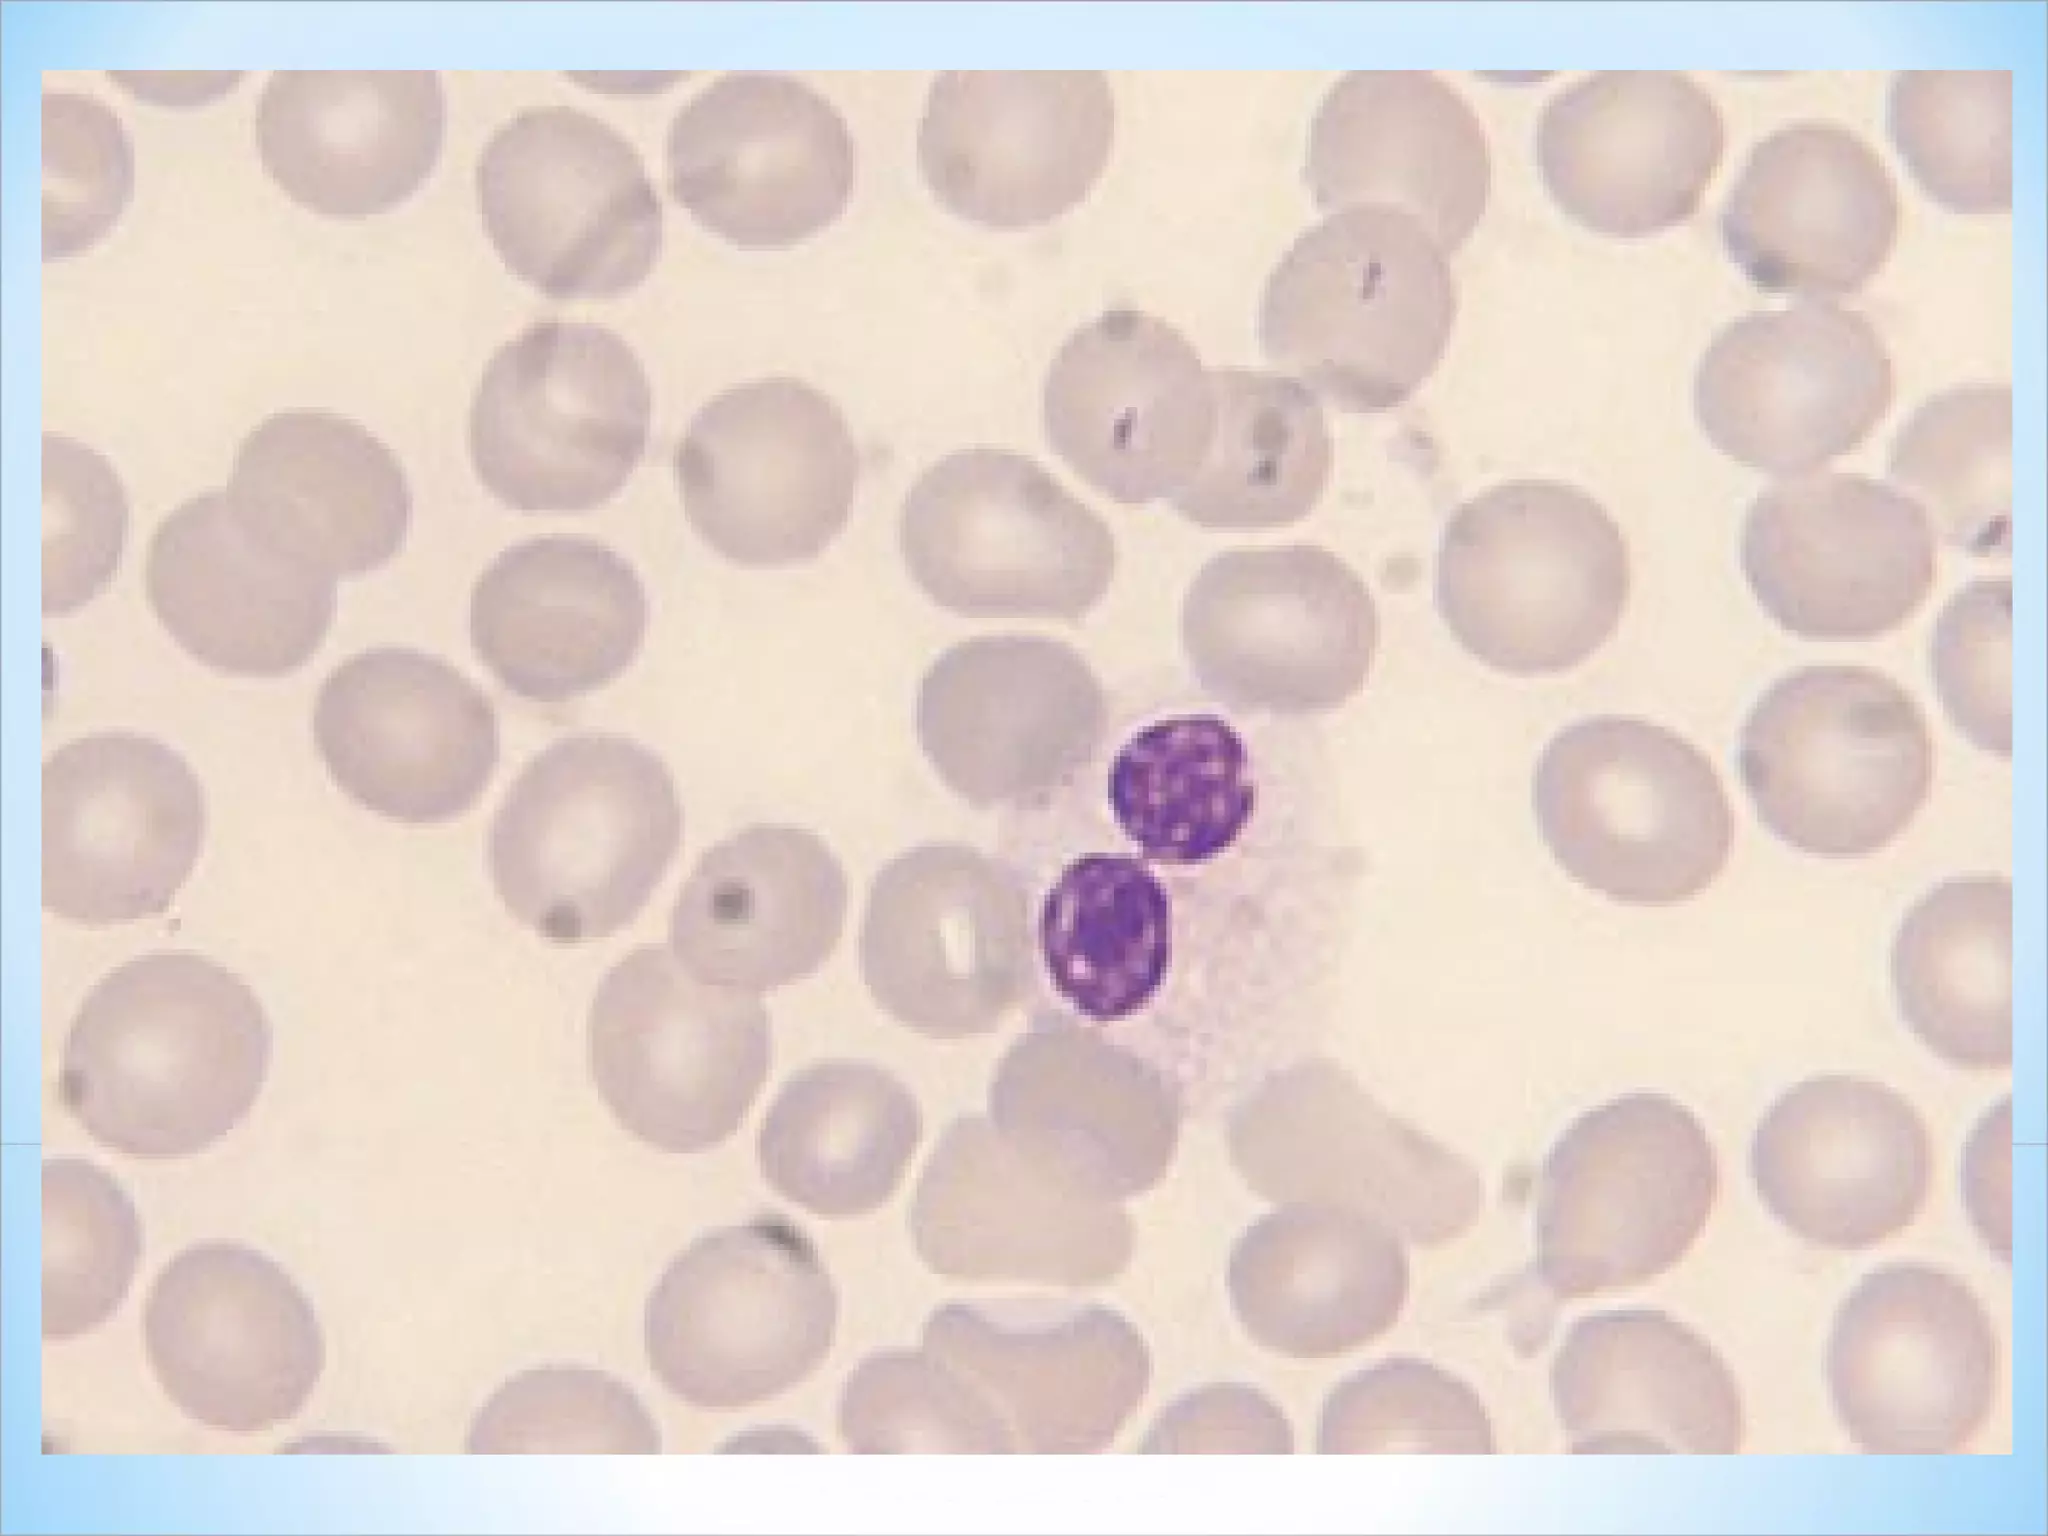
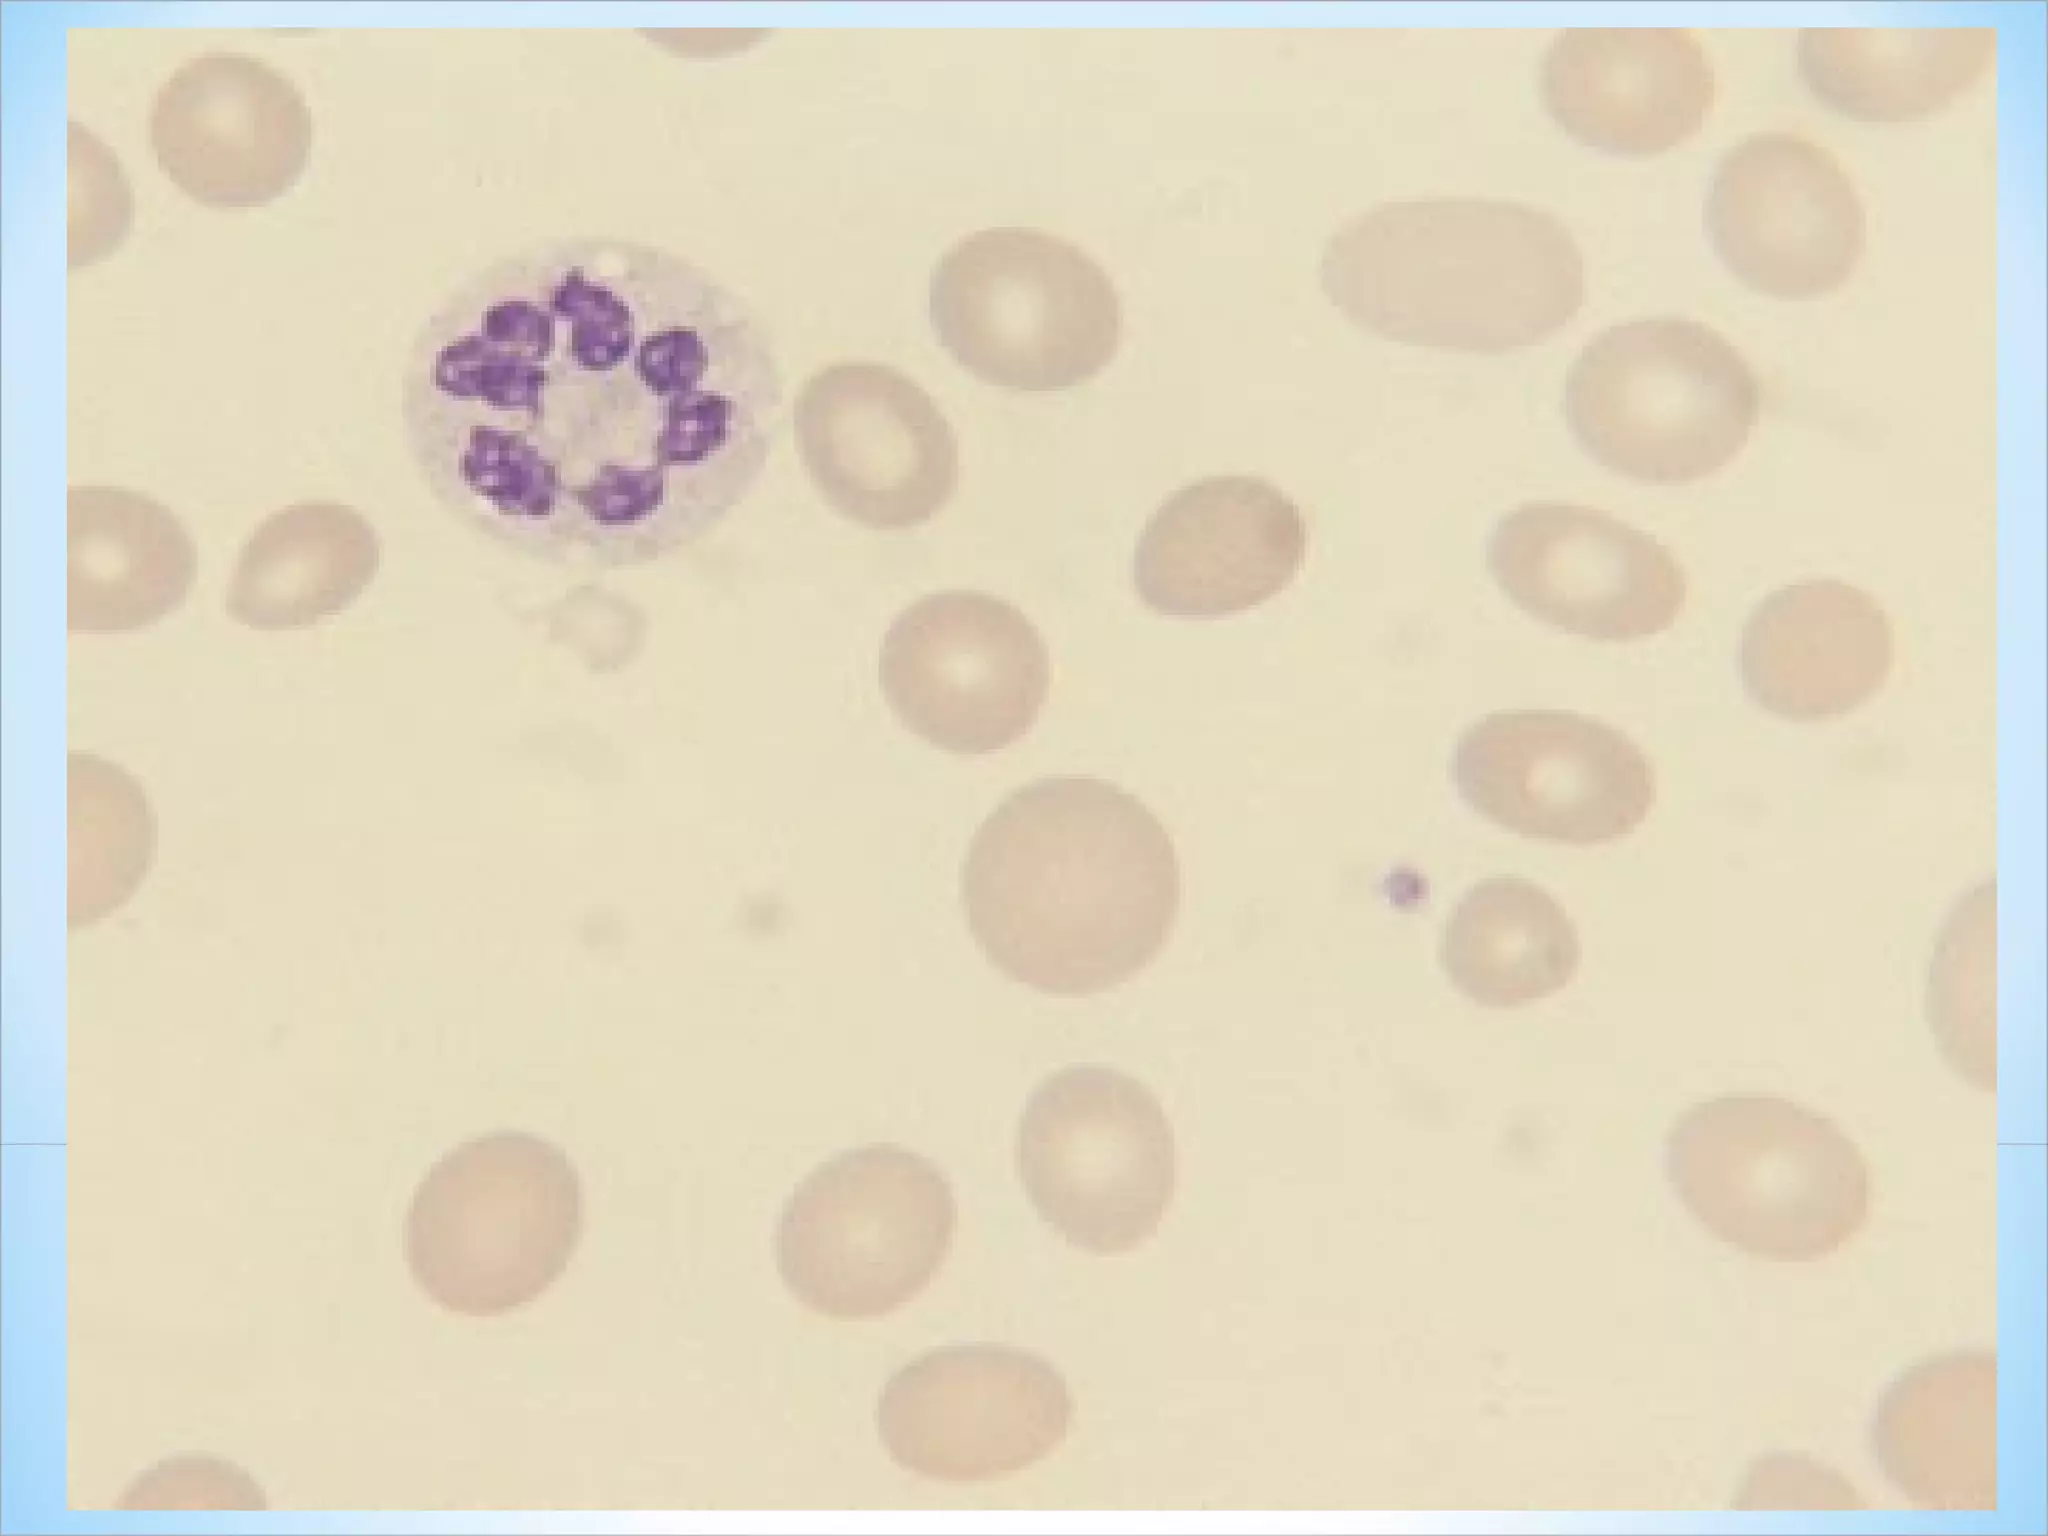
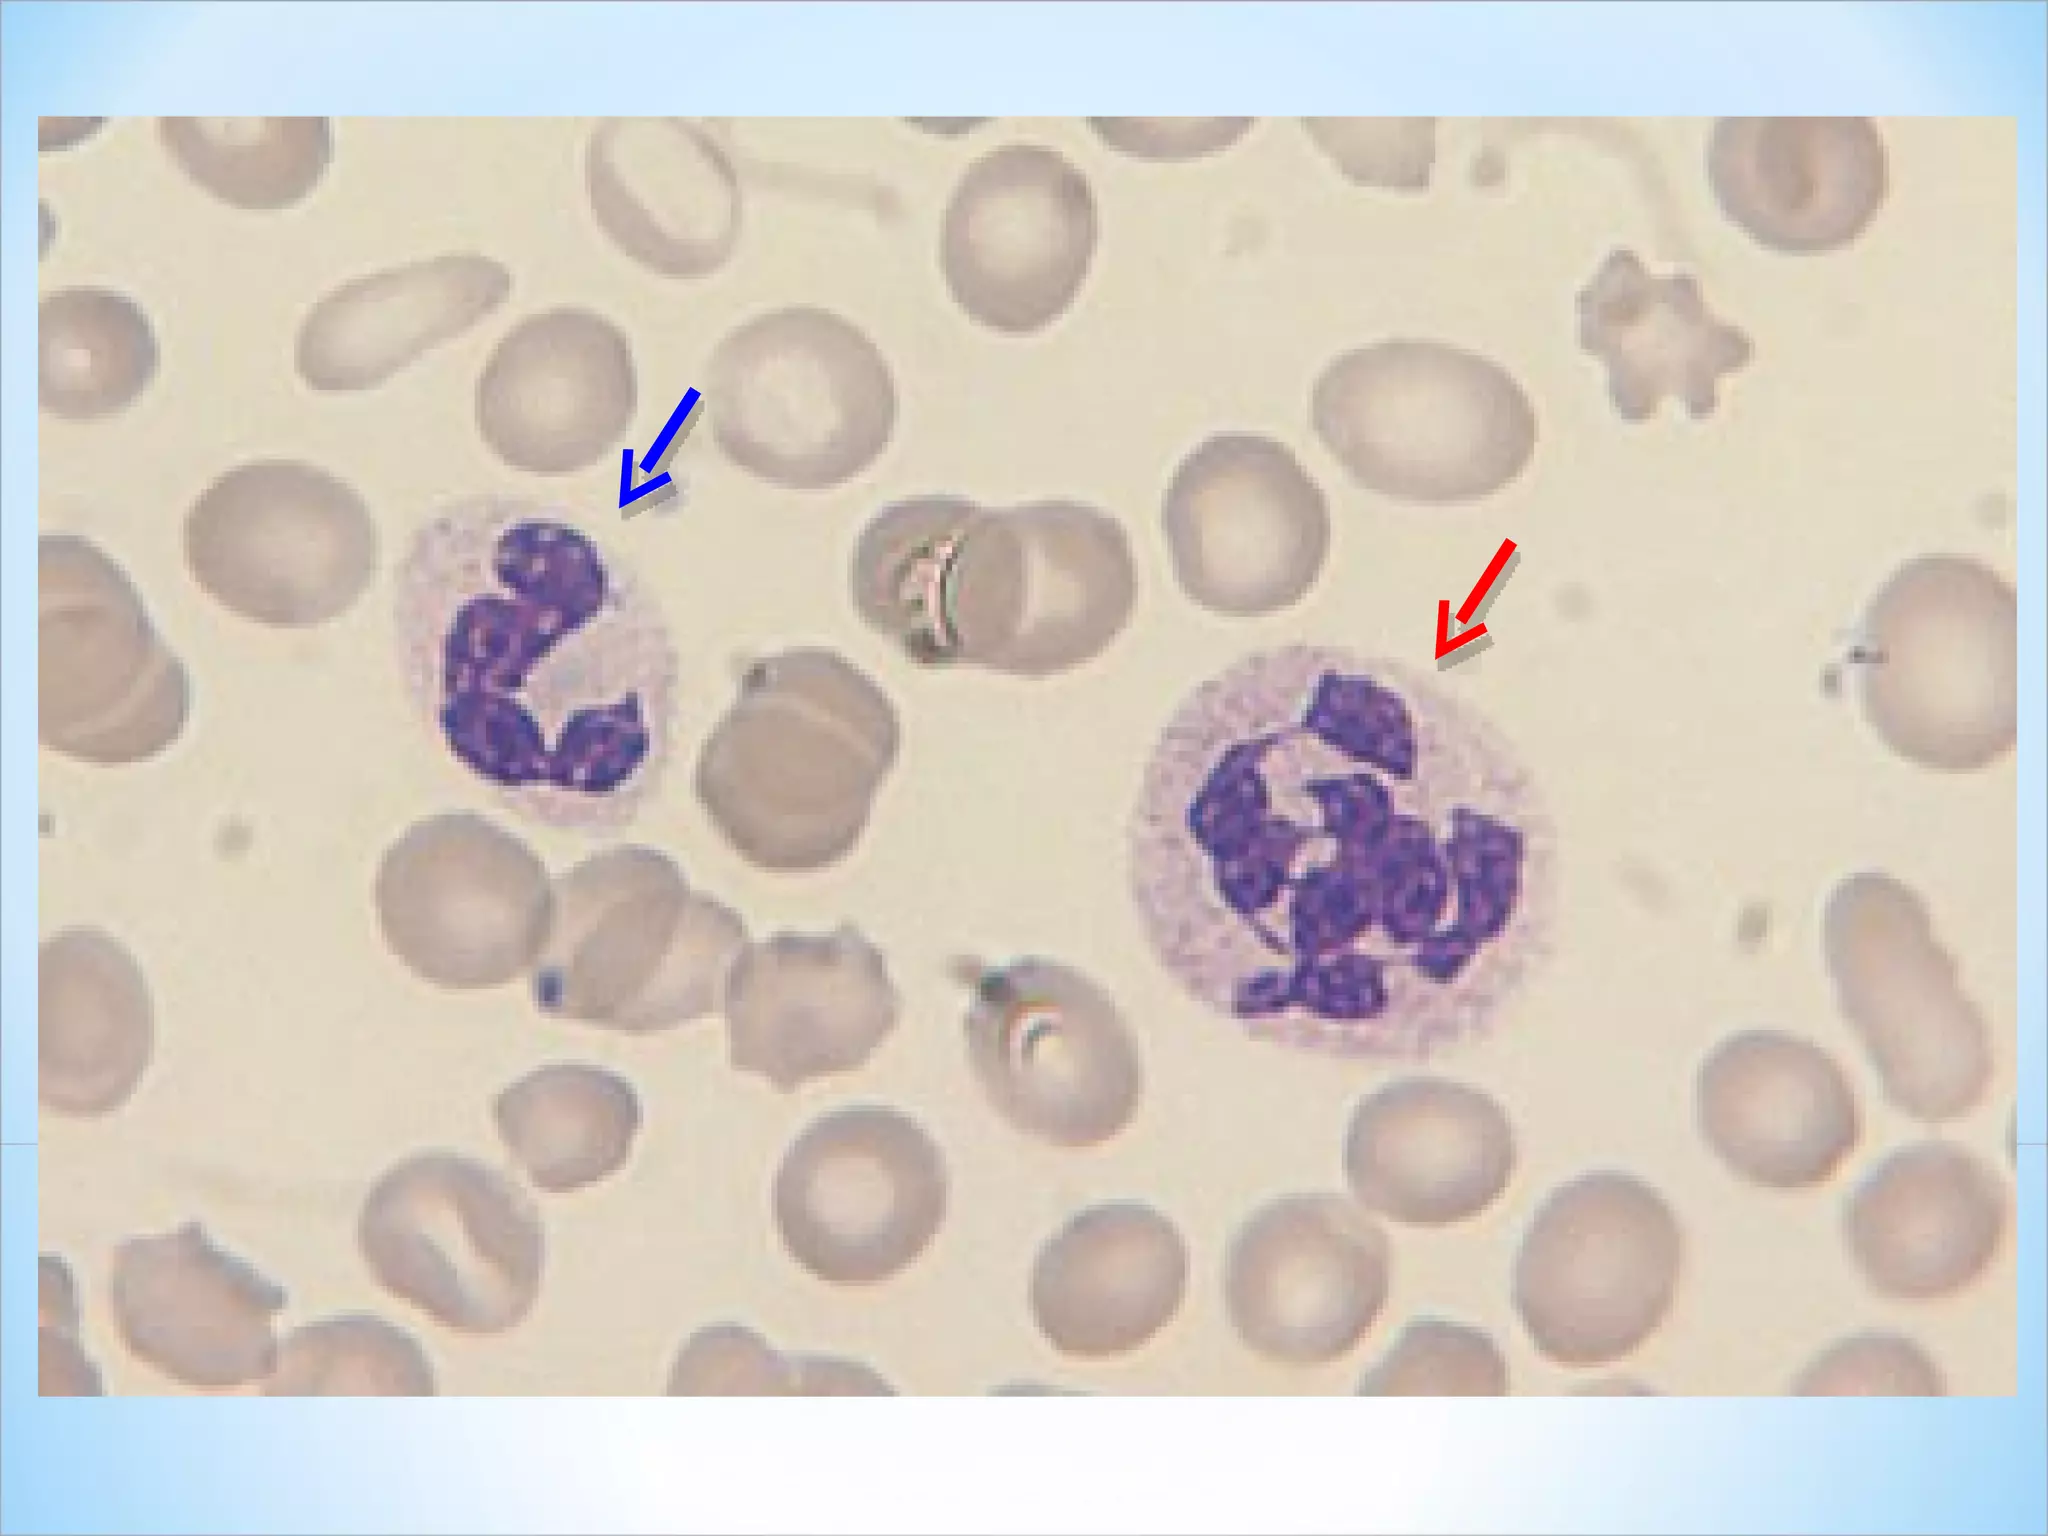
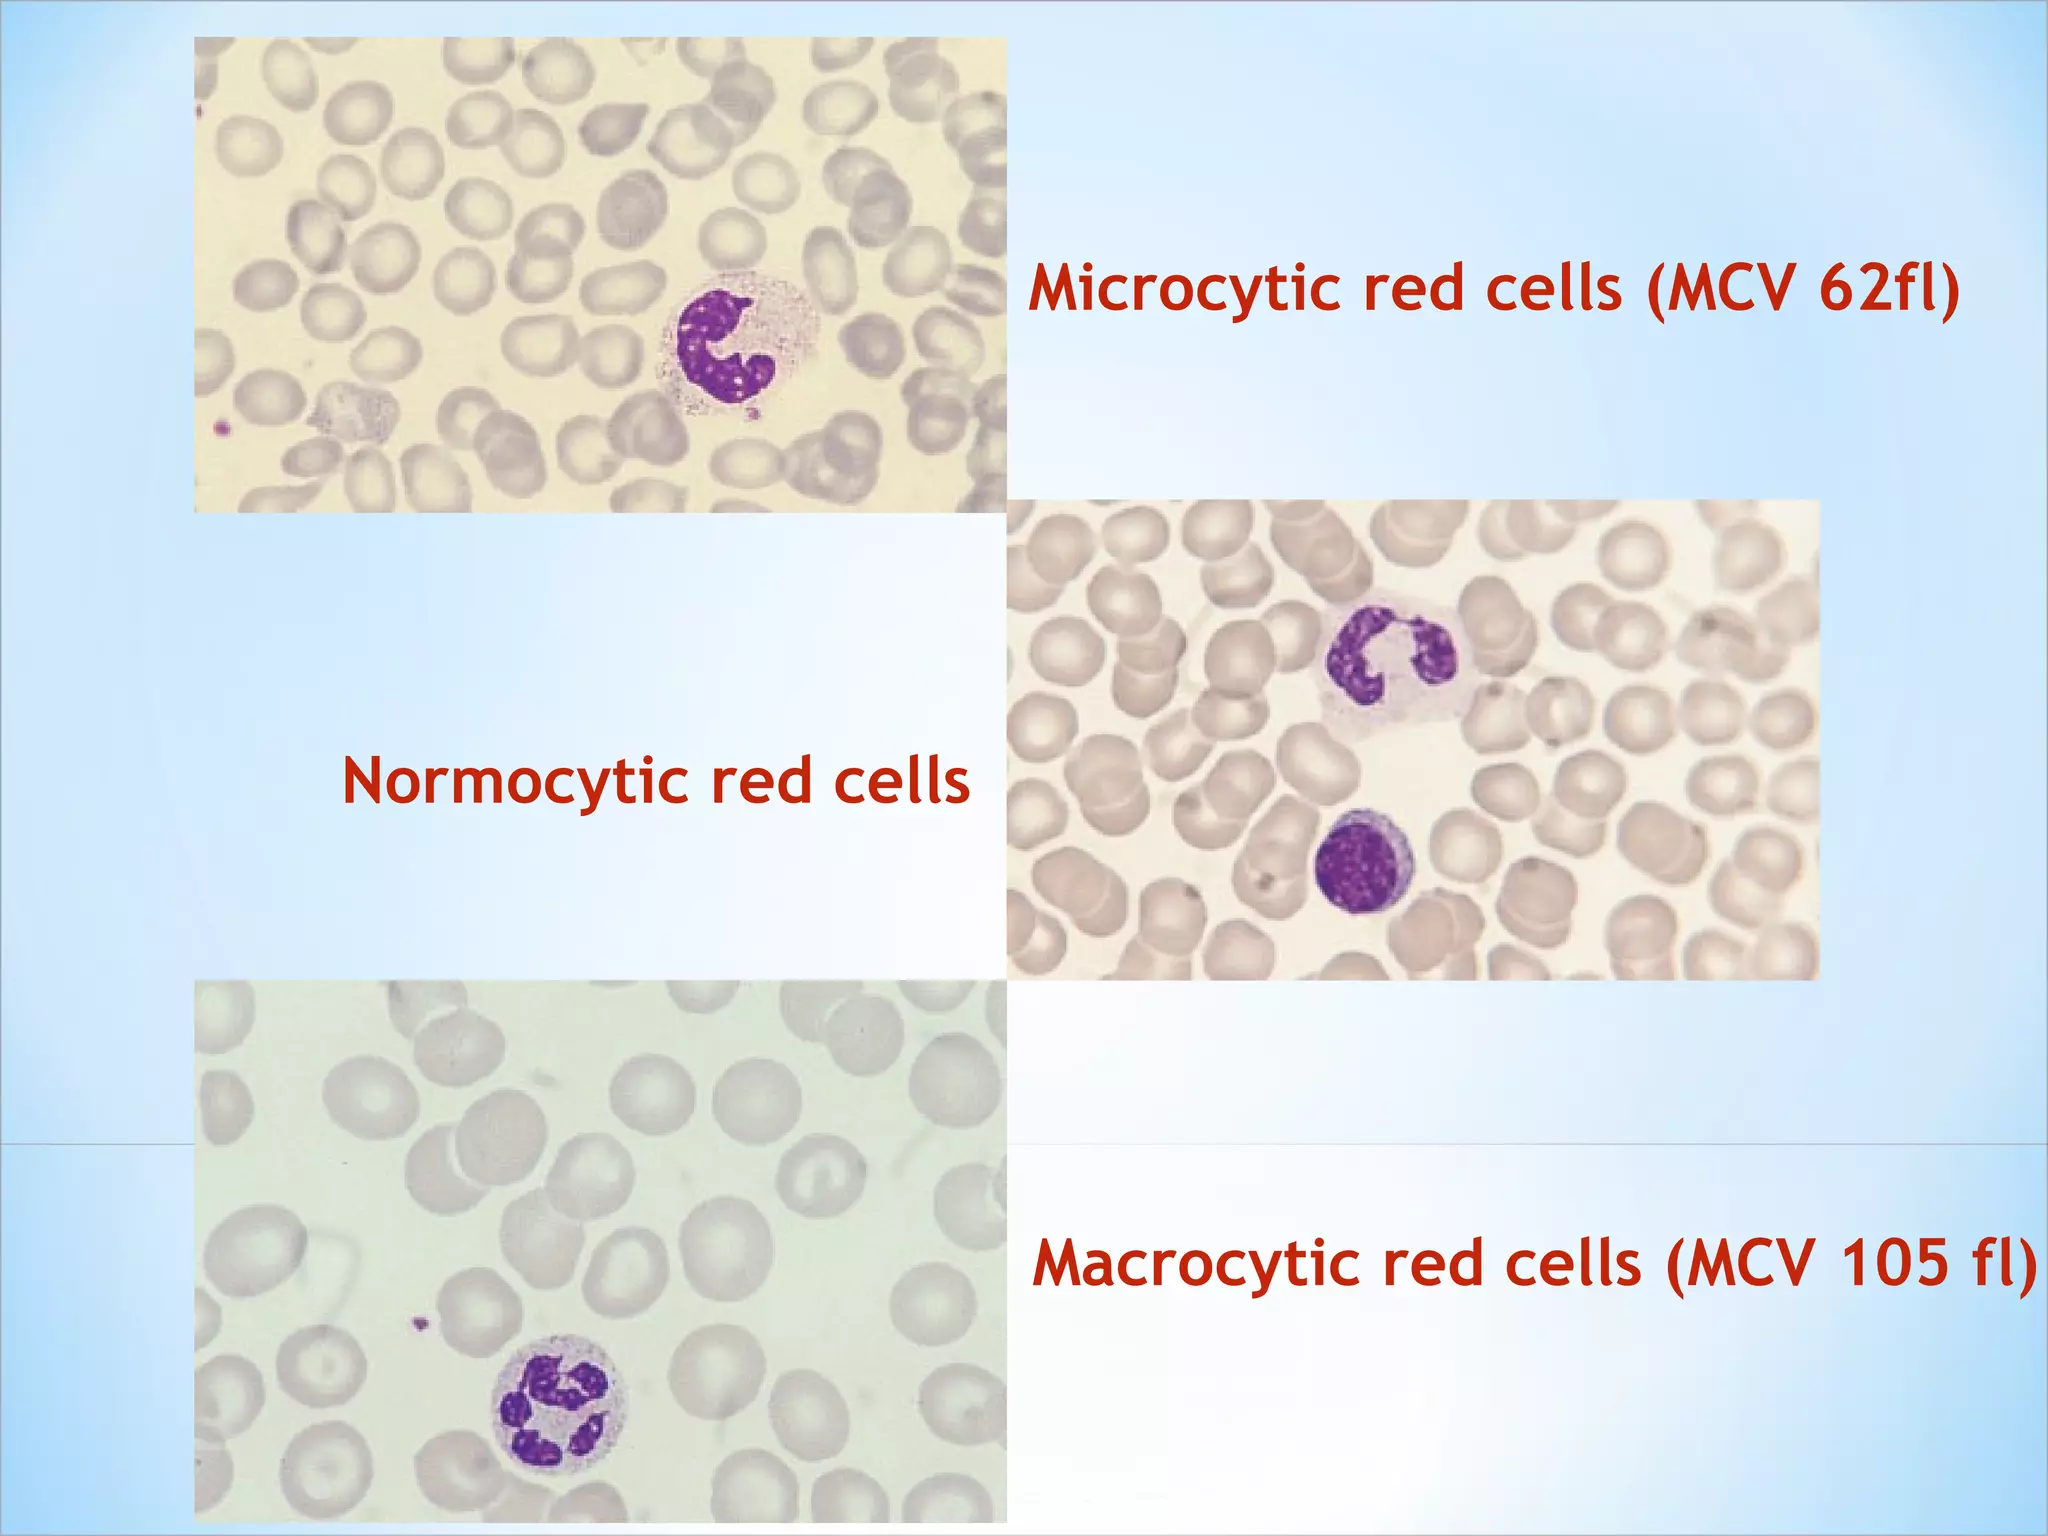
Microcytic red cells (MCV 62fl) Normocytic red cells Macrocytic red cells (MCV 105 fl)

The document discusses various components of a basic blood test. It provides details on the normal composition and functions of blood, as well as procedures for blood specimen collection. It also explains the clinical implications and reference ranges for various components analyzed in a complete blood count test, including red blood cells, white blood cells, platelets, hematocrit, hemoglobin, and sedimentation rate.

![5. Hemoglobin; Hb Main component of erythrocytes Vehicle for O 2 and CO 2 transportation The O 2 -combining capacity is directly proportional to [Hb] Hb determination is important Evaluation of anemia Determine severity of anemia Treatment response monitoring Evaluation of polycythemia Clinical implications: DECREASED vs INCREASED](https://image.slidesharecdn.com/hemapractical-02hematology-110215081623-phpapp01/75/Hema-practical-02-hematology-33-2048.jpg)

![Mean Corpuscular Volume (MCV) – index of single erythrocyte volume (fL) MCV (fL) = Hct (%) X 10 RBC (10 12 /L) Mean Corpuscular Hemoglobin Concentration (MCHC) – average [Hb] in RBCs MCHC (g/dL) = Hb (g/dL) X 100 Hct (%) Mean Corpuscular Hemoglobin (MCH) – average Hb weight per RBC MCH (pg/cell) = Hb (g/dL) X 10 RBC (10 12 /L)](https://image.slidesharecdn.com/hemapractical-02hematology-110215081623-phpapp01/75/Hema-practical-02-hematology-40-2048.jpg)





